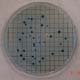

MICROBIOLOGICAL
ANALYTICAL |
Introduction
|
Different
types of microorganisms can be found in natural waters: viruses,
bacteria, cysts, spores, and worm eggs. Some of these organisms
can cause disease in animals and or humans, and so it is important
to test the quality of drinking water to ensure that it is safe
to drink. Different techniques in different places have been applied
in our research to test for microbial contamination.
We
use relatively simple, yet established, laboratory methods to test
for indicator organisms. The presence of indicator organisms, such
as E.coli, indicate the presence of waterborne pathogens.
Indicator organisms are measured rather than specific pathogens
since there are far too many pathogens to test for in a given water
sample. The 2 types of microbiological tests which are frequenly
used by students in the field are:
- Presence/Absence
(P/A) Test
- Membrane
Filtration (MF) Test
And
the indicator organisms that tested for with these methods are:
- Total
coliform
- Fecal
colifom
- E.coli
P/A
tests are easier to implement than membrane filtration tests; however,
membrane filtration tests allow the technician to enumerate the
number of bacteria colonies per sample volume rather than simply
testing for the presence/absence of indicator organisms. Both tests
require minimum equipment and are well-suited for use in field conditions.
|
Presence/Absence
Test
|
The
P/A test tests for the presence/absence of indicator organisms in
a water sample. This is usually observed in the form of a color
change after an incubation period. Two common P/A tests are:
- H2S-producing
bacteria P/A test
- Total
Coliform and E.coli P/A Test
H2S
producing bacteria P/A Test
As
described in the work of Manja et al.1, the screening
for H2S producing bacteria is a good indication of fecal contamination
in the sample. The test is relatively simple to carry out and requires
only 24-48 hours of incubation at 25°C. The sensitivity of the
test is, however, still debatable. Some research shows that positive
results will occur with bacteria concentrations as low as 1 CFU/100ml2,
while others show 5 CFU/100ml3 or more. MIT students
have used the pre-packaged H2S PathoScreen Medium by HACH
for P/A testing. The following lists the equipment and procedures
for carrying out the P/A test:
Instruments/reagents
|
- 20ml
glass sampling bottle
- candle
- lighter
- alcohol
- nail-clipper
- HACH
PathoScreen Medium for 20ml
|
 |
Procedures
|
- Sterilize
sampling bottle in air oven at 170°C for 1 hour or autoclave
at 15psi and allowed to cool.
- Pour
approx. 20ml sample into sampling bottle and allow sample to
stand for 15 minutes.
- Wipe
medium satchet with rubbing alcohol and flame cutting edge (scissors
or nail clipper) for sterilization.
- Cut
medium sachet and pour into sample bottle. Cap and mix.
- Place
sample at about 25°C (or room temperature).
- Take
H2S Bacteria P/A reading at 24 and 48 hours (Black = Positive,
Yellow = Negative).
|
 |
- Manja,
M.; Maurya, S.; Rao, K. M. (1982) Simple field test for the
detection of faecal pollution in drinking water. Bulletin WHO
60:797-801.
- Pillai,
J.; Mathew, R. G.; Ho, G. E. (1999) H2S paper strip method
a bacteriological test for faecal coliforms in drinking water
at various temperatures. Wat. Sci. Tech. Vol. 40, No. 2, pp.403-407.
- Grant,
M. A.; Ziel, C. A. (1996) Evaluation of a simple screening test
for fecal pollution in water. Journal Water SRT Aqua.
Vol. 45, No.1, pp. 13-18.
Total
Coliform and E.coli P/A Test
The
P/A test for total coliform and E.coli is carried out using
the HACH Lauryl Typtose with Bromcresol Purple (LT/BCP) Broth with
MUG reagent for 100ml sample. Similar to the H2S test, this test
can be carried out easily under the same conditions and results
can be obtained after 24-48hrs.
Instruments/reagents
|
- 100ml
glass bottle
- candle,
lighter, alcohol
- UV
lamp
- HACH
Lauryl Typtose with Bromcresol Purple (LT/BCP) Broth with MUG
reagent for 100ml sample
|
 |
Procedures
|
- Sterilize
sampling bottle in air oven at 170°C for 1 hour or autoclave
at 15psi and allowed to cool
- Pour
approx. 100ml sample into 100ml sampling bottle and allow sample
to stand for 15 minutes.
- Wipe
broth bottle with rubbing alcohol for sterilization.
- Break
broth bottle and pour into sample bottle. Cap and mix.
- Place
sample at about 25°C (or room temperature).
- Take
Total Coliform P/A reading at 24 and 48 hours.
- Murky
Yellow
= Positive, Purple = Negative.
- Take
E.Coli P/A reading with UV lamp at 24 and 48 hours.
- Fluoresce
= Positive, No fluoresce = Negative.
|
 |
Membrane
Filtration Test
|
The
membrane filtration test is a fast, simple way to estimate bacterial
population in water. In the initial step, an appropriate sample
volume is passed through a membrane filter with a pore size small
enough (0.45µm) to retain the bacteria present. The filter
is then placed on an absorbent pad (in a petri dish) saturated with
a culture medium that is selective for coliform growth. The petri
dish is inverted and placed in an incubator for 24hrs at the appropriate
temperature. After incubation, the colonies that have grown are
identified and counted with a magnifying glass.
Currently,
our team uses Millipore
products for its membrane filtration tests. The 2 tests that are
being used are:
- Total
coliform and E.coli: m-Coliblue24 broth on 0.45µm filter
paper @ 35°C for 24hrs.
- Fecal
coliform: m-FC broth on 0.7µm filter paper @ 44.5°C
for 24hrs.
Total
Coliform and E.coli MF Test
Instruments/Reagents
|
- MILLIPORE
portable MF setup
- m-Coliblue24
medium
- OXFORD
pipette
- candle,
lighter, tweezers
- incubator.
|

 |
Procedures
|
- Pour
m-Coliblue24 medium onto absorbent pad in petri dish. Decant
extra medium and label.
- Flush
approx. 30ml of distilled water through filter once.
- Place
0.45µm filter paper with sterile tweezers.
- Pipette
specified volume of sample into funnel. Stir.
- Run
filtration.
- Rinse
funnel with approx. 30ml of distilled water.
- Remove
filter carefully with sterile tweezers and place into petri
dish.
- Invert
and place petri dish into incubator set at 35°C for 24hours.
- Count
number of colony forming units (CFU) under magnifying class
and expressed as CFU/100ml.
- Blue
= E.coli, Red+blue
= Total coliforms (see image at right)
|
 |
Note:
We typically use m-Coliblue24 broth rather than m-Endo broth, which
we used to use for the enumeration of total coliform, because the
colonies show up clearer thus making counting easier. The m-Endo
broth requires the colonies to either show a silver metallic sheen
or appear very dark red in color in order to be counted as total
coliforms (see image at right). Based on experience, the results
are seldom that obvious and require a lot of judgment during interpretation.
|
 |
Fecal
Coliform Membrane Filtration Test
A
similar procedure is carried out for the MF test for fecal coliform.
The differences are:
- Use
0.7µm filter paper
- Use
m-FC broth
- Incubate
at 44.5°C
|
Fecal
colonies will appear dark blue (see
image at right). |
|